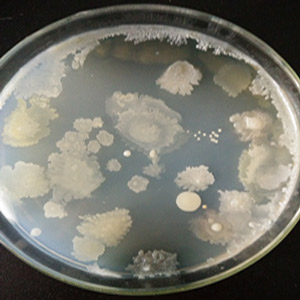
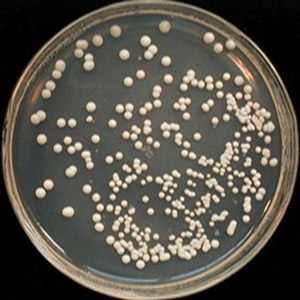

海博微信公众号
海博微信公众号
 海博天猫旗舰店
海博天猫旗舰店


 海博微信公众号
海博微信公众号
 海博天猫旗舰店
海博天猫旗舰店




1)培养基平皿表面水珠凝聚,造成涂布培养后菌落蔓延无法计数。
2)培养后计数结果超标。
3)培养后没有逐日观察,造成菌落生长成团,无法计数或计数结果统计错误。
2、原因分析及解决措施
情况①:培养基平皿表面水珠凝聚的原因在于浇碟的时候,培养基温度高,在平皿表面会形成水珠。
解决措施:培养基平皿表面水珠凝聚
◆培养基制备
培养基制备的一般流程:
①上午10点开始用干粉培养基天平称重,11点20开始灭菌,13:00开锅,在灭菌锅中冷却至13:30。
②将对照培养基置于50℃水浴锅中待用。
知识点:灭菌锅灭菌结束时,需要及时开锅,避免培养基长时间在灭菌锅中缺氧,造成培养基品质下降,培养基适用性失败且影响实验结果。
◆培养基浇碟
50℃水浴锅取出后,一般5分钟之内将培养基浇置空平皿中。平皿冷却后,观察培养基表面有无水珠,若无水珠则可直接进行涂布操作。多余的培养基可以放置在生物安全柜中或置密封袋(不是呼吸袋)里2-8℃保存。
若有水珠,若需要当天使用则打开平皿盖,轻轻甩掉表面的水珠,在运行的生物安全柜中放置0.5-1h直到表面没有水珠,然后进行涂布计数。
若不需要当天使用:
直接放置在生物安全柜中,盖上平皿,生物安全柜关机,7天内使用。
装入自封袋中保存在2-8℃冰箱中,2周内使用。使用前,提前一天取出,使平皿中水珠自动蒸发消失。
情况②:培养后计数结果超标的原因在于菌悬液制备不均匀。
每次制备的时候要涡旋3000转30s,使用前再涡旋3000转10s。特别是黑曲霉和白色念珠菌这种容易在底部沉底的菌,尤其需要注意。
情况③:培养后没有逐日观察,造成菌落生长成团。
无法计数或计数结果统计错误,可以参考下图解决这个问题。

文章来源:微信公众号微生物菌种网
提醒:本文章所有内容均来源网络,仅用于学习交流,若有侵权内容,请及时联系删除或修改,特此声明!
上一篇:发酵生产中常采用的pH调整措施
下一篇:生产常见的液体培养



